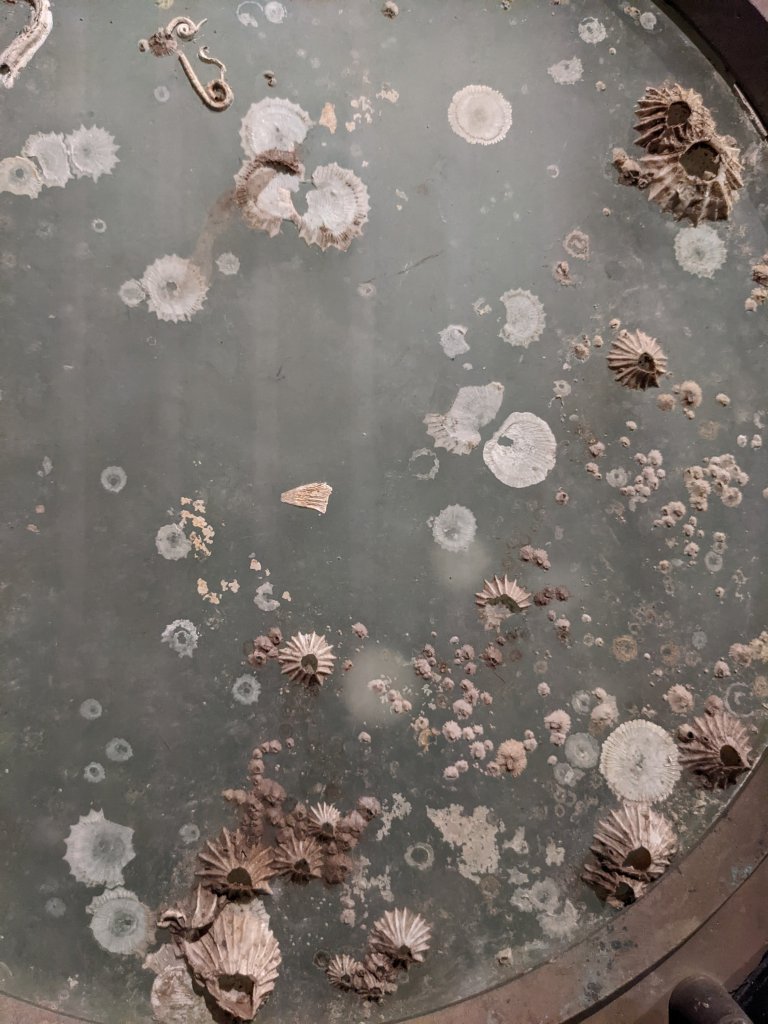

Over the summer holidays I have been inspired by working in orkney and visting not only skara brae but excavation sites,cairns,ancient graveyards and other such oddities.What interested me more then anything was the objects from these sites that could not be explained.What were they?Nobody seemed to know but rough guesses were they were used for some kind of games.

I also visited Crete for a week before i returned to uni and visited the palace of knossos.One of the oldest discovered palaces.What particualry intersted me was not only the paintings which would of been done super quick whilst the plaster was drying but the vast amount of findings which had been stored at the Herakilion museum such as clay objects with there arms risen up in a cult like worship,giant burial vases one which showed the skelton still inside it.A board game with the rules unknown.I realised that it wasn’t what was known that interested me but what wasn’t.Which is what give me such a morbid obsession with death because there is so much that is unknown in regards to after we die but the greeks has such a fascination with it that they made up a whole universe and characters that would look after you after death such as Thanatos who would come to carry you off when your time given by the fates had expired.Objects made to look like this god were also to be found in this museum.










Returning to uni I found it really hard to get into the swing of things so decided to help inspire myself and my morbid curiosity that i would take myself to Surgeons Hall (a place i have never visted even after 10 years of living in Edinburgh) it was extemely worth a vist with miles and miles of basicaly body parts in phthalimide that had either suffered certain fates or had a tumour/disase,tumor,bones and other such items of morbid curiosities.Unlike the Greek/neolithic findings there was much known about these findings.Photo’s weren’t allowed for the obvious reason of the items being body parts but sketches were. One item I found particualry interesting as random as it may seem was the rib sternum in particular the shape it inspired me and made me think of what a wonderful headpiece the shape of the sternum would make,I thought of this,the god Thanos and prehaps an alternate surreal universe where a cult of white clothed figures lived,the leader where the rib sternum as a had piece.




After recently having watched ‘Keep sweet:Pray and obey’ I thought of how all the morman women were required to dress the same.Same hairstyle,clothing etc within a particular sect a polygamous Fundamentalist Church of Jesus Christ of Latter-Day Saints, an offshoot of mainstream Mormonism.The women were required to do a dance infront of the men in order to ‘keep them sweet’ and what if this particular cult of white clothed figures did the same.
A world where nothing is quite understood we can only guess,a world of darkness,mystery,weirdness and alure.I felt that last semesters work was too dark and heavy and it made me miss the light surreal tones of the semester before.So I feel like moving forward I wanted to mix the best of both worlds altho I haven’t yet worked out if i want there to be a serious message behind this cult (prehaps about removal of female identity?) or just completely nonsensical but this will be something that i imagine will come to light as I work further through the project.
My first stop tho is to make the rib sternum into a headpiece.My first consideration is whether or not I should first make a maquette from card or not and how much of the rib sternum I want to make,do i want the ribs included or just the sternum?Should i make a maquette of both and which would have most impact?
After painting out one of the creatures in black ink I felt that it would transfer really well into waterless lithography which is a technique i tried out last year due to the bold and gestural paintmarks.



Tomorow i have a visit to the Hawkhill museum college and hope to take sketches of further odditities particualry from the pathology department to add to my research collection.
















































































:no_upscale()/cdn.vox-cdn.com/uploads/chorus_image/image/61078135/slender_man.0.jpeg)



















